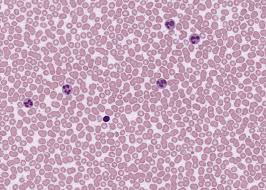
knowt flashcard image

Tissue Structures and Functions
1/24
There's no tags or description
Looks like no tags are added yet.
Name | Mastery | Learn | Test | Matching | Spaced | Call with Kai |
|---|
No analytics yet
Send a link to your students to track their progress
25 Terms
epithelial tissues
ectoderm, endoderm, and mesoderm
simple squamous tissue
thin, flat cells; inner lining of arteries, veins, and body cavities; single layer

simple cuboidal tissue
square with a nucleus; single layer

simple columnar tissue
goblet cells; single layer

pseudostratified columnar tissue
goblet cells; cilia; single layer but looks multilayered

stratified squamous tissue
stacks of the thin, flat cells

areolar tissues
fibers, loose connective tissue, collagen, elastic tissue, used to connect skin to muscle
areolar tissue

adipose tissues
found in arteries, veins, and nerves; fat
adipocyte
fat cell
adipose tissue

cartilage tissues
trachea slide, have matrix (surrounding area), lacunae (cavities where chondrocytes are found)
cartilage tissue

bone tissues
have lacunae (cavities), canaliculi (canals that connect lacunae), osteons (single sections), osteon canals, and are made of osteocytes
bone tissue

blood tissues
has plasma (clear, mainly water, light), erythrocytes (red), leukocytes (white), and platelets (thrombocytes)
blood tissue
smooth muscle tissues
non-striated, involuntary (middle/outer layers of intestine, middle layer of blood vessels, vein, and nerve)
smooth muscle tissue

skeletal muscle tissues
striated, voluntary, multinucleate
skeletal muscle tissue

cardiac muscle tissues
striated, involuntary, intercalated discs
cardiac muscle tissue

nervous tissues
neurons, neuroglia, dendrites and axons, cross section of nerve
nervous tissue
